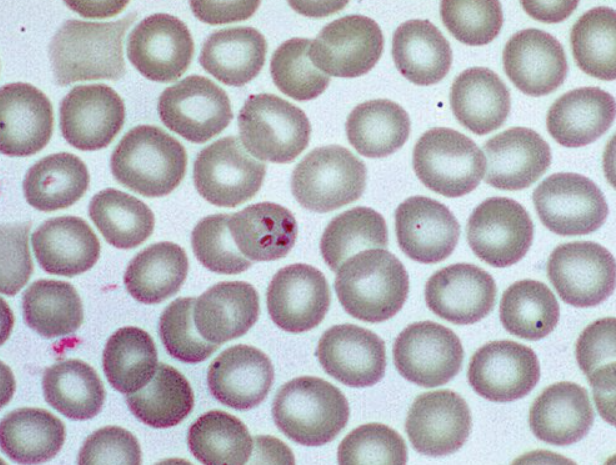
Pasted image 20230731103448.png|400

Babesiosis
Presentation :
- Symptoms typically begin within 1 month after tick bite and within 2 months after transfusion of infected blood products.
- Symptoms are nonspecific and include fever (89%), fatigue (82%), chills (67%), headache (47%), myalgia (43%), and cough (28%).
- Physical examination may reveal jaundice, hepatomegaly, and splenomegaly, which rarely progresses to splenic rupture.
- The hallmark of babesiosis is hemolysis, with anemia almost invariably present. Severe disease may include thrombocytopenia, elevated serum aminotransferase levels, and acute kidney injury.
Pathophysiology :
- Caused by the intraerythrocytic protozoan Babesia microti, which is spread by Ixodes scapularis (Blacklegged Deer Tick).
- Can also occur in non-endemic regions via infected blood transfusions
Diagnostic Testing:
- Visualization of B. microti, manifesting as intraerythrocytic ring forms similar to those seen in malaria OR as tetrads resembling a Maltese cross, on thin blood smears is diagnostic.
- With low-level parasitemia, the sensitivity of microscopy is poor. Therefore, polymerase chain reaction should be pursued if the clinical suspicion of babesiosis is high.
- Antibody testing does not differentiate acute from previous infection and is not recommended for diagnosis.
Treatment :
- The first-line treatment for babesiosis is atovaquone plus azithromycin.
- In patients intolerant of this regimen, clindamycin plus quinine is an alternative.
- Exchange transfusion may be indicated in patients with severe infection and high-grade (>10%) parasitemia.
- Immunocompromised patients require a longer treatment duration, typically 2 weeks after documented clearance of parasites on blood smear.
| Severity | Regimen |
|---|---|
| Mild to moderate disease | Atovaquone plus oral azithromycin for 7-10 days |
| Severe disease requiring ICU admission | Atovaquone plus IV azithromycin for 7-10 days |
| Highly immunocompromised patients | Atovaquone plus high-dose azithromycin (500-1000 mg) for at least 6 weeks |
Prognosis:
References:
- MKSAP
Created at: periodic/daily/July/2023-07-31-Monday